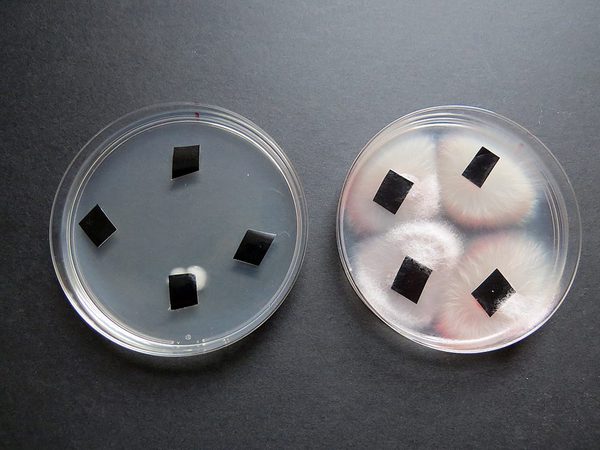

- Alla nyheter
- Jordbruk
- Skogsbruk
- EU
- Globalt
- SLC
- Opinion
- Maskin & teknik
- Landsbygdsnäringar
- Marknad
- Livet på landet
- Veckans Tok
- Tema
- Yle


– Det är klart man har ett intresse för lantbrukspolitik. Besluten påverkar ju direkt vår egen näring, säger SLC Nylands nyvalda andra viceordförande, Joel Rappe.

Årets kvalitetsproducenter av grönsaker Martin och Carola Sigg i Pjelax har alltid gått i bräschen för ny teknik. I början av 2000-talet var de bland de första att börja med konstbelysning. De var också tidigt ute med LED som sedan 2014 används på hela odlingsytan. Läs mer i veckans Trädgårdstema!
Välfungerande trädgårdsföretag med god ekonomi som har möjlighet att utveckla sin verksamhet är väsentliga för att trygga tillgången på inhemska grönsaker, bär och frukter, konstaterar Nina Sevelius, utvecklingschef för trädgårdsproduktion, SLF.

Lill-Bred i Ingå satsar i år på att förlänga jordgubbssäsongen rejält. Det nyuppförda växthuset på 360 kvadratmeter ska fyllas med plantor i slutet av februari.
Trots att växthusnäringens lönsamhet har varit svag under senare år finns framtidstro. Åtminstone enligt Kantar TNS Agri Oy:s undersökning som visar att många av företagarna som deltog i enkäten planerar att bygga ut.
Uppstartföretaget Happico Oy har i samarbete professor Risto Tahvonen utvecklat användningen av ozonvatten i produktionen av trädgårdsväxter. Nu erbjuder företaget tekniska helhetslösningar för vattenrening med ozon i växthus. I sommar fortsätter utvecklingsarbetet.

Det danska uppstartföretaget Nordic Harvest är snart redo att starta Europas största vertikala trädgårdsodling i Taastrup utanför Köpenhamn. Grödorna odlas i hydrokultur i fjorton våningsplan.

Sibbo är en av landets snabbast växande kommuner. Mitt i kommunens centrum, Nickby, står en ståtlig jubilar – Söderbloms trädgård. Handelsträdgården firar i år sitt sjuttioårsjubileum. Trädgården drivs i tredje generation.

Rosensallat, den i Italien så populära grönsaken (radicchio) produceras inte i någon större skala i Finland. Då vissa av sorterna behöver en köldknäpp för att få rätt smak kunde de var intressanta att odla här i Finland för att skördas på senhösten.

Det fläktar och blåser ofta på kullen invid Reksjön i Terjärv där Eivor Duvnäs i snart sex år ägnat sig åt en osedvanlig bärodling. Området kring Gistö gård är naturskönt, ett fredat kulturlandskap med kuperad terräng, och ett ypperligt läge för de 11.000 rosenbuskar som senaste säsong gav en handplockad skörd av uppemot 4.000 kilo nypon.

Marc Bock är andra generationens biodlare med västeuropeiska rötter. Allt från naturmaterial till ekologiskt socker förutsätts för ekocertifiering inom biodling.
